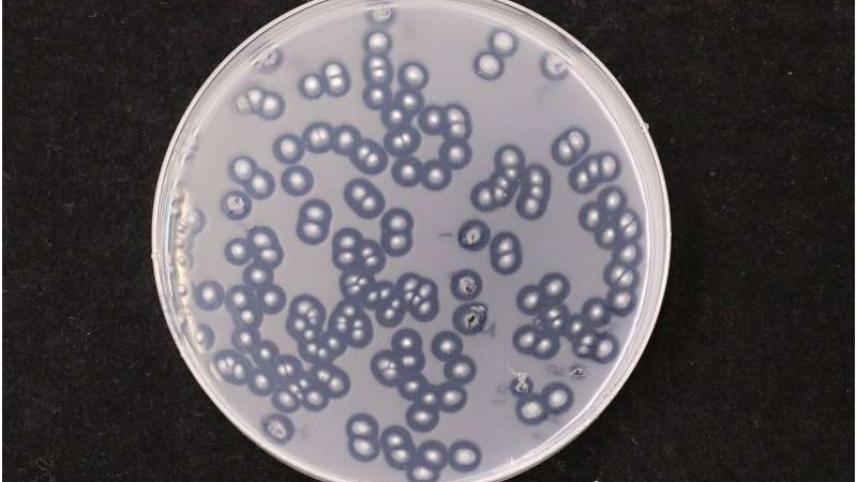
fungi

Plastic-eating fungi found in Chinese coastal salt marshes
An international team of scientists identified plastic-eating bacteria and fungi in Chinese coastal salt marshes, presenting new possibilities for global waste management, according to a study published today.
"A total of 184 fungal and 55 bacterial strains capable of breaking down" various plastics were found in the Jiangsu province of eastern China, the Royal Botanic Gardens in Kew said in a statement.
Researchers from China and the UK in May 2021 sampled microorganisms from China's Dafeng, a UNESCO-protected site near the coast of the Yellow Sea.
They found a distinct "terrestrial plastisphere", described as a "man-made ecological niche", which is an ecosystem that has evolved to live with the presence of coastal plastic debris.
"Scientists are increasingly looking at microorganisms, such as fungi and bacteria, to help tackle some of the most pressing challenges of the modern age, including the rising tide of plastic pollution," Kew Gardens said.
The new findings contribute to existing studies on plastic-degrading microorganisms with some 436 species of fungi and bacteria found capable of breaking down plastic to date, it added.
"Kew scientists and partners believe their latest findings could lead to the development of efficient enzymes designed to biologically degrade plastic waste," it went on.
In 2020, approximately 238 million metric tonnes of waste from short-lived plastics -- such as packaging that ends up in municipal waste -- was generated worldwide, according to a recent report from the United Nations Environment Programme.
Roughly half of that was mismanaged -- for example dumped in the environment or burned.
Later this month, representatives from nearly 200 countries will meet in Paris for a new round of negotiations aimed at reaching a legal agreement next year to end plastic pollution.



 For all latest news, follow The Daily Star's Google News channel.
For all latest news, follow The Daily Star's Google News channel. 
Comments